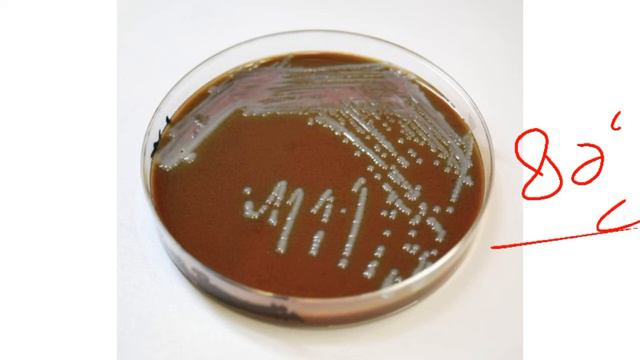
Neisseria meningitidis laboratory diagnosis| Hindi /Urdu animation @thestreamofknowledge смотреть онлайн

Автор / Канал: Spreading Kindness Страница 15

Прохождение GTA San Andreas на 100% - Миссия 77: Ключ к её сердцу

Английский ЕГЭ:Словообразование.Префикс in. Новые слова быстро и легко. Prefix in vocabulary.

бед Варс блокмен го, но каждые 5 секунд игра быстрее

Как связана реализация с другими сферами жизни? Почему не получается ощущать удовлетворение ?

Не знаю, чего хочу

МОДЕЛИ ОТВЕЧАЮТ НА ВОПРОСЫ В БУТЫЛОЧКУ | Шоу историй про моделинг | Часть 2
Neisseria meningitidis laboratory diagnosis| Hindi /Urdu animation @thestreamofknowledge

line problems (Technical drawing) pt 8

Ryse: Son of Rome. Русская версия. PC Max Settings, без субтитров и комментариев. Эпизод 1/11
![Lesson #8. Звук [ə] / Курс по произношению Read Propely / Звуки английского языка смотреть онлайн Lesson #8. Звук [ə] / Курс по произношению Read Propely / Звуки английского языка смотреть онлайн](https://pic.rtbcdn.ru/video/22/67/2267454ba4d5cfd178469b185f279add.jpg)
Lesson #8. Звук [ə] / Курс по произношению Read Propely / Звуки английского языка

Мужские наручные часы Слава сделано в СССР 27 камней

Твой продукт будут покупать, если ты будешь знать об этом

Info Viabilità Pavese - Bollettino n.25 settimana 49 - Da Lunedì 5 Dicembre a domenica 11 dicembre

Чужих детей не бывает...

Вспышечная Активность Солнца, Магнитные БУРИ

Injured WWE Star Career OVER?! Free Agent AEW Title Match?! WWE Legend On Life-Support

Lollipop Song | Ice Cream Song - Baby Children Songs - Nursery Rhymes & Kids Songs

не знаю, может на следующей неделе видео не будет.. :( #simsaburka

ТЕС практика-Как да помогнем на себе си и децата си за лекота и високи постижения в училище и живот

Como Activar Cortana En Latino America Windows 10 (Colombia)

Мой дневной макияж

НЕРЕАЛЬНЫЕ ПРАНКИ НАД БРАТОМ ИЛИ СЕСТРОЙ | Смешные розыгрыши и Пранки

MFC-J6710DW Brother Colour Inkjet Multi-Function Center

почему нужно помогать больным людям?
За каждым успешным каналом стоит личность, идея и сотни часов кропотливого труда. Если вы здесь, значит, автор «Spreading Kindness» уже сумел зацепить ваше внимание своим уникальным стилем или подачей. А мы на RUVIDEO позаботились о том, чтобы вы могли изучить весь архив его работ в максимально комфортных условиях — без лишней суеты и преград.
Почему за работами канала «Spreading Kindness» так интересно наблюдать? Всё просто: это честный контент, который находит отклик в сердцах зрителей. На нашем ресурсе вы можете смотреть онлайн все видео любимого автора бесплатно и в хорошем качестве. Нам важно, чтобы вы видели каждую деталь и слышали каждый нюанс, поэтому мы используем только стабильные плееры из открытых источников Rutube.
Следите за новинками канала, пересматривайте старые шедевры и открывайте для себя новые грани творчества «Spreading Kindness». Мы постоянно обновляем ленту, чтобы у вас под рукой всегда были самые свежие выпуски. Никаких сложных регистраций — только вы и творчество, которое вдохновляет. Приятного вам путешествия по миру авторского контента на RUVIDEO!
Видео взято из открытых источников Rutube. Если вы правообладатель, обратитесь к первоисточнику.